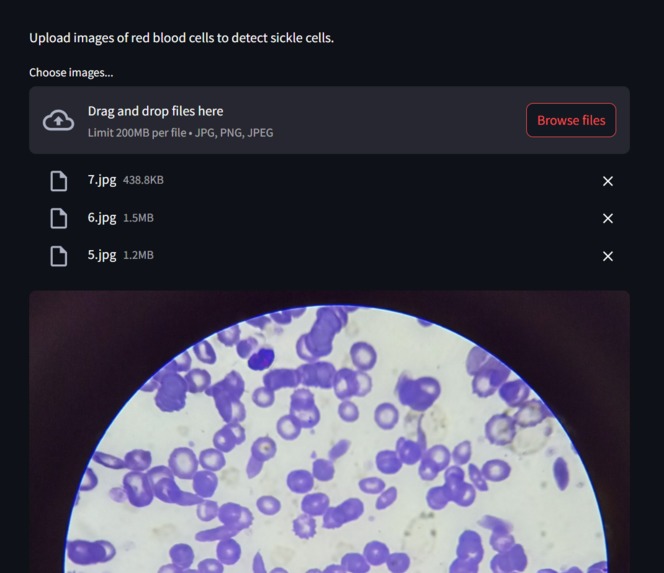
Sickle Cell Detector – screenshot 3

The Sickle Cell Disease Detector: A Story of Inspiration and Innovation Inspiration:
The inspiration for the Sickle Cell Disease Detector stemmed from a stark realization: the disproportionate impact of sickle cell disease on India's tribal communities. The statistics were alarming, and the stories like Raju's, of delayed diagnosis and unnecessary suffering, were heartbreaking. I was particularly moved by the idea that access to healthcare, or lack thereof, could determine a child's future. The potential to leverage technology, specifically AI, to bridge this healthcare gap and bring timely diagnosis to remote areas became a powerful driving force.
What I Learned:
This project was a deep dive into the intersection of healthcare, AI, and social impact. I learned:
The complexities of sickle cell disease: Understanding the disease's pathology, its genetic basis, and the challenges of diagnosis in resource-limited settings was crucial. The power of image processing and machine learning: I gained hands-on experience in training AI models to analyze microscopic blood images, identifying the characteristic sickle-shaped red blood cells. The importance of accessible technology: Designing a tool that could be deployed in remote areas required careful consideration of factors like internet connectivity, device compatibility, and user-friendliness. The crucial role of early diagnosis: I learned the significance of early detection in managing sickle cell disease, preventing complications, and improving patient outcomes. The importance of working with communities: To implement this tool successfully, it would be vital to work with tribal communities and healthcare workers to ensure that the technology is adopted and used effectively. How I Built the Project:
The project involved several key stages:
Data Collection: Gathering a substantial dataset of microscopic blood images, both healthy and sickle cell affected, was the first step. Image Preprocessing: This involved cleaning, enhancing, and segmenting the images to isolate individual red blood cells. Model Training: I utilized convolutional neural networks (CNNs) to train an AI model to recognize sickle cells based on their shape and morphology. User Interface Development: A simple, intuitive interface was designed to allow healthcare workers to easily upload blood images and receive diagnosis results. Deployment Planning: Consideration was given to deployment on mobile devices or cloud-based platforms to ensure accessibility in remote areas. Challenges Faced:
Data Scarcity: Obtaining a large, diverse dataset of blood images was a significant challenge. Image Variability: Microscopic images can vary in quality due to factors like lighting, staining, and equipment. Model Accuracy: Achieving high accuracy in sickle cell detection required fine-tuning the AI model and addressing potential biases. Accessibility and Implementation: Ensuring the tool's accessibility in remote areas, where internet connectivity and healthcare resources are limited, posed a significant challenge. Ethical Considerations: Ensuring patient privacy and data security was paramount. This project was a challenging but incredibly rewarding experience. It reinforced my belief in the power of technology to address pressing social issues and improve lives.
Built With
- python
- streamlit
- tensorflow

Log in or sign up for Devpost to join the conversation.